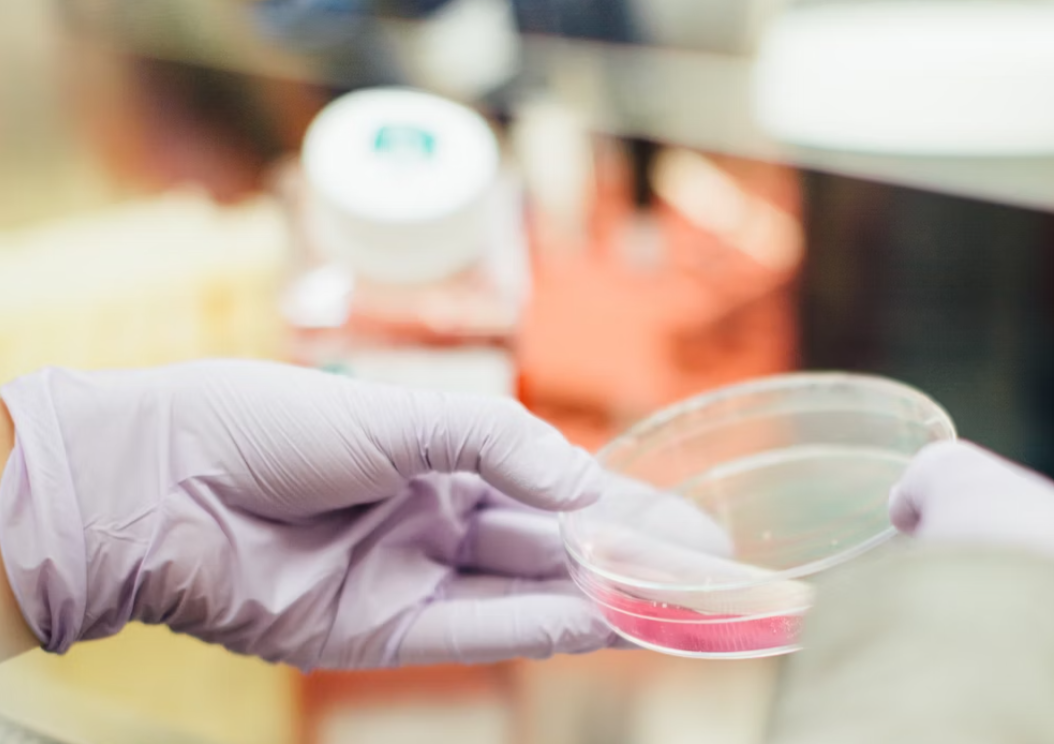

Why Now is the Perfect Time to Emphasize Dividend Stocks: 3 Key Reasons
The recent resurgence of volatility in the stock markets, this time caused by problems with some American and European banks, serves as a reminder for investors of the importance of diversifying their portfolios and the significance of dividend stocks.
In this article, we will discuss why dividends are currently attractive, and we will provide a overview of several stocks worth considering for their dividend yields.
The Appeal of Dividend Stocks
According to Callum Thomas of TOPDOWN CHARTS, dividends are now appealing for three main reasons:
- The decline in stock prices offers access to relatively certain regular income at better prices.
- Higher dividend yields on developed markets outside the US provide investors with an opportunity for broader regional diversification.
- Historical experience suggests that dividends can be an interesting protection against high inflation.
What kind of dividend stock are good picks in current envinvironment?
Last year, Mike Morey of Integrity Viking Funds outperformed 95% of his competitors by focusing on stocks of companies that pay solid dividends and have strong cash flows. Founded in 1987, Integrity Viking Funds has incorporated dividend stocks into its many financial products.
Traditionally, strong cash flows have been generated by US companies in the healthcare sector and consumer staples (necessary goods and services).
Here are a few dividend stocks to consider in these industries:
Health-care
ABBV: AbbVie is a global biopharmaceutical company that researches, develops, and markets advanced therapies for complex and serious diseases, including autoimmune disorders and cancer. The company focuses on innovation and a robust pipeline to deliver new products in very regulated and complicated environment.
BMY: Bristol-Myers Squibb is a global biopharmaceutical company dedicated to discovering, developing, and delivering innovative medicines for patients with serious diseases, primarily in the areas of oncology, immunology, and cardiovascular disease. The company's strategy is centered on combining internal R&D capabilities with external partnerships and acquisitions. For example in recents years company acquired Turning Point Therapeutics, Forbius and MyoKardia.
MRK: Merck is a multinational pharmaceutical company that specializes in developing and producing prescription medicines, vaccines, biologic therapies, and animal health products. The company's business strategy emphasizes research-driven innovation.

Consumer Staples - Soft drinks
KO: Coca-Cola is a global beverage company that produces and distributes a wide range of non-alcoholic beverages, including soft drinks, water, juices, and ready-to-drink teas and coffees. The company's business strategy focuses on maintaining brand strength which belongs amongst the most valuable brand names in the world.
PEP: PepsiCo is like Coca-cola a multinational food and beverage company. It's business strategy is a bit more agressive than KO and it centers around diversifying product offerings and gaining new markets arounds the world.

Consumer Staples - Tobacco
MO: Altria is a a U.S.-based tobacco company that primarily focuses on the domestic market. Its product portfolio includes leading cigarette brands such as Marlboro but it offers wide variety of tobacco products, including smokeless tobacco, and cigars. It’s future strategy focuses on investments in the e-cigarette and cannabis markets. For example spent $1.8 billion for a 45 percent stake in Cronos Group - Cannabinoid company that focuses on research and development of cannabis products.
BATS: British American Tobacco is based in the United Kingdom with focus on a global presence – operating in over 180 markets worldwide. Its product portfolio includes various cigarette brands such as Lucky Strike or Dunhill. BAT's strategy focuses on product innovation and investment in reduced-risk products. Company is currently number one product of vaping products.
PM: Philip Morris International PMI is a global tobacco company with headquarters in the United States and Switzerland, operating in numerous international markets. PMI was originally a part of Altria before being spun off as a separate entity in 2008. Much of company focuses is on heated tobacco products like IQOS and on transforming its product portfolio to focus on smoke-free alternatives.
If you want to add these companies to your portfolio or you already have them - you can use our dividend portfolio tracker - which will monitor dividend performance in long-term including dividend safety score, payout ratios, divdiend growth and your yield on cost.